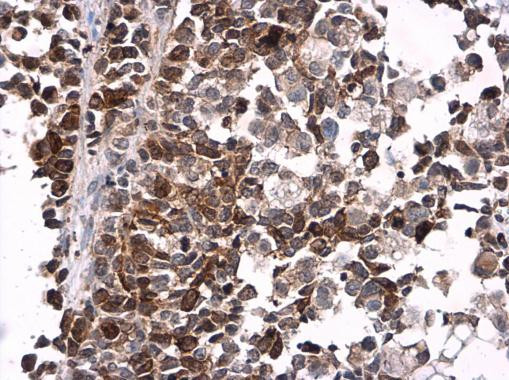
Phospho-CDK1 (Tyr15) Antibody in Immunohistochemistry (Paraffin) (IHC (P))

Search
Invitrogen
Phospho-CDK1 (Tyr15) Polyclonal Antibody
{{$productOrderCtrl.translations['antibody.pdp.commerceCard.promotion.promotions']}}
{{$productOrderCtrl.translations['antibody.pdp.commerceCard.promotion.viewpromo']}}
{{$productOrderCtrl.translations['antibody.pdp.commerceCard.promotion.promocode']}}: {{promo.promoCode}} {{promo.promoTitle}} {{promo.promoDescription}}. {{$productOrderCtrl.translations['antibody.pdp.commerceCard.promotion.learnmore']}}
图: 1 / 5
Phospho-CDK1 (Tyr15) Antibody (PA5-85508) in IHC (P)





产品信息
PA5-85508
种属反应
已发表种属
宿主/亚型
分类
类型
抗原
偶联物
形式
浓度
规格
纯化类型
保存液
内含物
保存条件
运输条件
RRID
产品详细信息
Keep as concentrated solution.
Predicted reactivity: Mouse (100%), Rat (100%), Zebrafish (100%), Japanese Medaka (100%), Drosophila (100%), Xenopus laevis (100%), Pig (100%), Chicken (100%), Sheep (100%), Rhesus Monkey (100%), Chimpanzee (100%), Bovine (100%).
Positive Control: HeLa (untreated), HeLa (2mM double thymidine treatment and recovery for 3.5hr), HeLa (2mM double thymidine treatment and recovery for 12hr), HeLa (100 ng/mL Nocodazole treatment for 24hr), Rat-2 (untreated), Rat-2 (100 ng/mL Nocodazole treatment for 24.
Store product as a concentrated solution. Centrifuge briefly prior to opening the vial.
靶标信息
CDK1 or Cell Division Control protein 1 is essential for the completion of START, the controlling event in the cell cycle that is required to initiate mitosis. CDK1 is a catalytic subunit of a protein kinase complex, called the M-Phase Promoting Factor that induces entry into mitosis and is universal among eukaryotes. Phosphorylation of Bcl-2 in G2/M phase-arrested cells following photodynamic therapy with hypericin involves a CDK1-mediated signal and delays the onset of apoptosis. Therapeutic potential of CDK inhibitor NU2058 in androgen-independent prostate cancer has also been demonstrated.
⚠WARNING: This product can expose you to chemicals including mercury, which is known to the State of California to cause birth defects or other reproductive harm. For more information go to www.P65Warnings.ca.gov.
仅用于科研。不用于诊断过程。未经明确授权不得转售。
生物信息学
蛋白别名: ABL1; CDC2; cdc2 kinase; CDK1; Cdk1-PA; cell cycle controller CDC2; cell division control; Cell division control protein 2 homolog; cell division cycle 2, G1 to S and G2 to M; Cell division protein kinase 1; CG5363-PA; cyclin dependent kinase; cyclin-dependent kinase; Cyclin-dependent kinase 1; DKFZp686L20222; KCIP-1; LD38718p; MGC111195; MGC53829; OTTHUMP00000019660; P34 CDK1; P34 MGC111195; p34 protein kinase; Protein 1054; protein 2; unnamed protein product
基因别名: cdc; 5363; CDC2; CDC28A; cdc2Dm; CDCDm; Cdk-1; CDK1; CDK1/CDC2; CDKN1; CG5363; Dcdc2; dCdk1; Dm cdc2; DmCdc2; DmCdk1; Dmel\CG5363; Dmel_CG5363; group 4; l(2)31Eh; P34CDC2
UniProt ID: (Human) P06493, (Fruit fly) P23572
Entrez Gene ID: (Human) 983, (Fruit fly) 34411